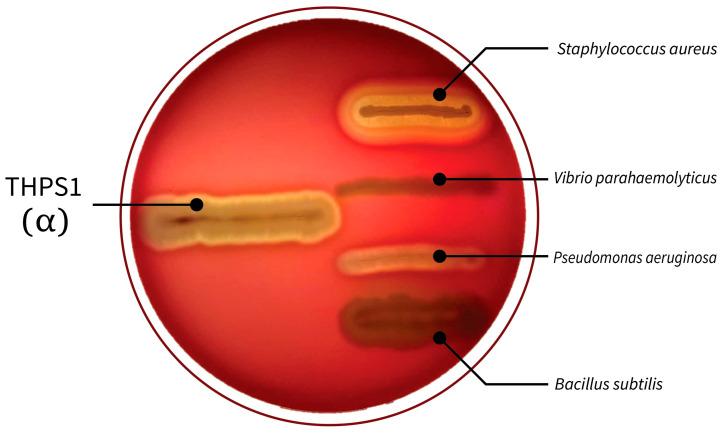
https://cdn.ncbi.nlm.nih.gov/pmc/blobs/c01a/11727782/403a05d65daf/microorganisms-12-02476-g001.jpg

嗜热栖热放线菌THPS1的基因组特征:一种具有功能特性和生物技术潜力的温泉来源菌种。
Genomic Characterization of sp. THPS1: A Hot Spring-Derived Species with Functional Features and Biotechnological Potential.
作者信息
Mwamburi Samuel Mwakisha, Islam Sk Injamamul, Dinh-Hung Nguyen, Dangsawat Orathai, Sowanpreecha Rapeewan, Khang Luu Tang Phuc, Montha Napatsorn, Therdtatha Phatthanaphong, Dwinanti Sefti Heza, Permpoonpattana Patima, Linh Nguyen Vu
机构信息
Kenya Marine and Fisheries Research Institute, Mombasa 80100, Kenya.
Department of Fisheries and Marine Bioscience, Faculty of Biological Science and Technology, Jashore University of Science and Technology, Jashore 7408, Bangladesh.
出版信息
Microorganisms. 2024 Dec 2;12(12):2476. doi: 10.3390/microorganisms12122476.
sp. THPS1 is a novel strain isolated from a high-temperature hot spring in Thailand, exhibiting distinctive genomic features that enable adaptation to an extreme environment. This study aimed to characterize the genomic and functional attributes of sp. THPS1 to understand its adaptation strategies and evaluate its potential for biotechnological applications. The draft genome is 5.38 Mbp with a GC content of 35.67%, encoding 5606 genes, including those linked to stress response and sporulation, which are essential for survival in high-temperature conditions. Phylogenetic analysis and average nucleotide identity (ANI) values confirmed its classification as a distinct species within the genus. Pangenome analysis involving 19 others closely related thermophilic species identified 1888 singleton genes associated with heat resistance, sporulation, and specialized metabolism, suggesting adaptation to nutrient-deficient, high-temperature environments. Genomic analysis revealed 12 biosynthetic gene clusters (BGCs), including those for polyketides and non-ribosomal peptides, highlighting its potential for synthesizing secondary metabolites that may facilitate its adaptation. Additionally, the presence of three phage regions and 96 mobile genetic elements (MGEs) suggests significant genomic plasticity, whereas the existence of five CRISPR arrays implies an advanced defense mechanism against phage infections, contributing to genomic stability. The distinctive genomic features and functional capacities of sp. THPS1 make it a promising candidate for biotechnological applications, particularly in the production of heat-stable enzymes and the development of resilient bioformulations.
嗜热栖热放线菌THPS1菌株是从泰国的一个高温温泉中分离出的新型菌株,具有独特的基因组特征,使其能够适应极端环境。本研究旨在表征嗜热栖热放线菌THPS1菌株的基因组和功能属性,以了解其适应策略并评估其在生物技术应用方面的潜力。该菌株的基因组草图为538万碱基对,GC含量为35.67%,编码5606个基因,包括与应激反应和孢子形成相关的基因,这些基因对于在高温条件下生存至关重要。系统发育分析和平均核苷酸同一性(ANI)值证实其被归类为该属内的一个独特物种。对另外19个密切相关的嗜热物种进行的泛基因组分析确定了1888个与耐热性、孢子形成和特殊代谢相关的单拷贝基因,表明其适应营养缺乏的高温环境。基因组分析揭示了12个生物合成基因簇(BGC),包括聚酮化合物和非核糖体肽的生物合成基因簇,突出了其合成可能有助于其适应的次级代谢产物的潜力。此外,三个噬菌体区域和96个移动遗传元件(MGE)的存在表明其基因组具有显著的可塑性,而五个CRISPR阵列的存在意味着其具有针对噬菌体感染的先进防御机制,有助于基因组稳定性。嗜热栖热放线菌THPS1菌株独特的基因组特征和功能能力使其成为生物技术应用的有前途的候选者,特别是在生产热稳定酶和开发有弹性的生物制剂方面。